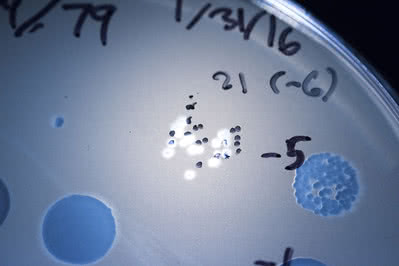

Support our science

Supporting Rockefeller University is one of the soundest investments you can make in the future of medical science. Whether you attend an event, join one of our programs, or make a gift, your support is essential.
Together, we can create a healthier world for today and for generations to follow.
 Learn about Rockefeller’s new strategic plan:
The Convergence of Science and Medicine.
Learn about Rockefeller’s new strategic plan:
The Convergence of Science and Medicine.